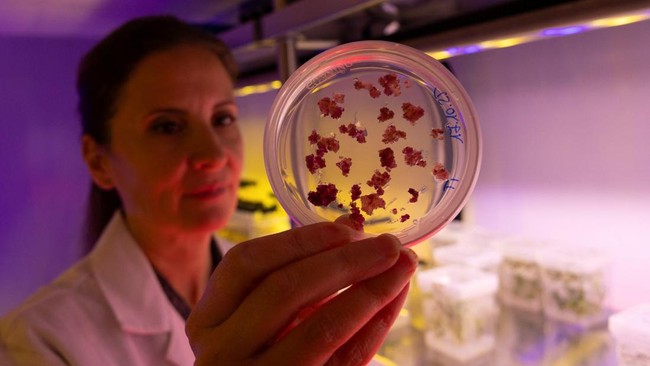

FOTO: Italia Ciptakan Camilan dari Sisa Buah dan Sel Tumbuhan
CNN Indonesia
Selasa, 16 Des 2025 15:30 WIB
Jakarta, CNN Indonesia --
Italia menciptakan camilan buatan menggunakan sisa buah dan sel tumbuhan. Mereka menggunakan printer 3D guna mencetak 'kue' bernutrisi.
Add
 as a preferred
as a preferred
source on Google
 as a preferred
as a preferred source on Google